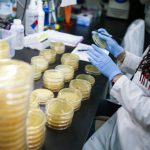

Регулаторната комисија која ја донесе Одлуката за корекција за цената, е независна и високо професионална институција која во изминативе 2 години направи и спроведе одлични реформи во својот делокруг. Оттука, веруваме дека нивните одлуки се професионално димензионирани во насока на заштита на интересите и на граѓаните и на компаниите.И со корекцијата на цената, Република С. Македонија и натаму има една од најниските цени на електрична енергија во регионот и во Европа, велат од СДСМ.
-Пандемијата со коронавирусот што ја зафати нашата земја но и целиот свет го погоди и енергетскиот сектор на глобално ниво. Потрошувачката на струја драстично се намали. Од друга страна, во овој период на вонредна состојба енергетскиот сектор одговори на задачата и граѓаните имаа струја постојано. Дополнително се покажа одговорност и во ваква состојба обезбедено е пролонгирано плаќање на сметките без камати, како и да нема исклучување од енергетските системи во време на вонредна состојба. Ова е резултат на здравите енергетски политики и континуираните инвестиции во зголемување на домашното производство и обезбедување на сигурна и стабилна испорака на електрична енергија, велат од СДСМ.
За да се задржи функционалноста на енергетскиот систем во вакви вонредни состојби за потрошувачката кои неминовно следуваат, цената на електричната енергија се корегира за 7,42% односно за сметка од 1500 денари ќе има корекција од околу 100 денари. За да се заштитат граѓаните евтината тарифа останува на сила во дневните и ноќни интервали исто како и до сега.
Преку евтината тарифа 15 милиони евра годишно остануваат кај граѓаните, а најголем дел од нив се социјално ранливите групи, пензионерите и невранотените лица кои најмногу ја користат оваа мерка. СДСМ во изминатите 3 години направи сериозни реформи во енергетиката. Се покажа дека реформскиот процес во енергетиката за заштита на потрошувачите, транзицијата на замена на јаглен со сонце- на обновливите извори на енергија и правото на избор се единствениот вистински пат кој гарантира отпорност на енергетскиот сектор и во вакви нови околности за сите, соопштуваат од партијата.